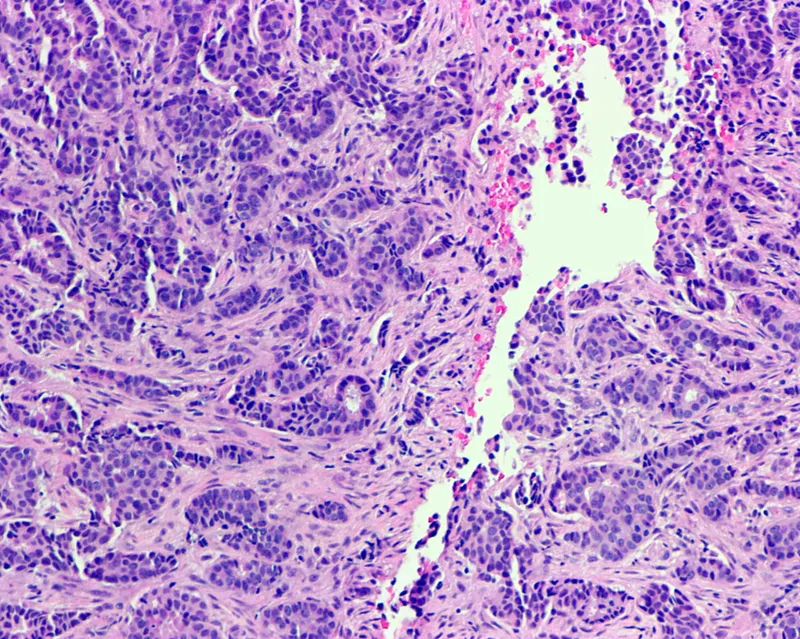
Invasive ductal carcinoma in male breast tissue (histology)

👨⚕️ Pathophysiology - Not Just for Ladies
- Core Mechanism: An increased Estrogen to Androgen ratio is the primary driver, stimulating ductal epithelial proliferation.
- Histology: Predominantly Invasive Ductal Carcinoma (IDC), >85% of cases.
- Lobular carcinoma is rare due to rudimentary terminal lobules in the male breast.
- Genetics: Strong association with BRCA2 mutations (higher risk than BRCA1).
⭐ Over 90% of male breast cancers are Estrogen Receptor (ER) positive. This makes endocrine therapy (e.g., Tamoxifen) a cornerstone of treatment.
👨⚕️ Clinical Manifestations - Lumps & Bumps

- Primary Sign: A painless, firm, non-tender, and fixed subareolar mass. This is the presenting symptom in >85% of men.
- Location: Typically located just beneath the nipple-areolar complex, but can be eccentric.
- Associated Signs: Common due to minimal breast tissue.
- Nipple retraction, inversion, or ulceration.
- Bloody or serosanguinous nipple discharge.
- Skin dimpling (peau d'orange), erythema, or fixation to the skin.
- Lymphadenopathy: Palpable axillary lymph nodes are a frequent finding, present in up to 50% of patients at initial diagnosis.
⭐ Because of the small amount of male breast tissue, tumors are more likely to invade the nipple-areolar complex, skin, and underlying pectoralis muscle early.
🩺 Diagnosis - Spotting the Suspect
-
Initial Evaluation: Any palpable, firm, subareolar mass in a male is the most common presentation.
- Assess for nipple retraction, bloody discharge, skin changes (dimpling, ulceration), or axillary lymphadenopathy.
-
Diagnostic Pathway:
- Biopsy:
- Core Needle Biopsy (CNB) is the gold standard. It provides tissue for histology and receptor testing (ER, PR, HER2).
- Fine-Needle Aspiration (FNA) is less preferred due to high inadequacy rates.
⭐ Pearl: Unlike in females, screening mammography is not recommended for asymptomatic men. Diagnosis is prompted by symptoms.
🔪 Management - The Surgical Strike
-
Primary Surgery: Modified Radical Mastectomy (MRM) is the standard of care. It involves removing the entire breast, nipple-areolar complex, and performing an axillary evaluation.
-
BCT is Rare: Breast-conserving therapy is seldom used due to small breast volume, which leads to poor cosmesis and high rates of positive margins.
-
Axillary Staging: Essential for prognosis and guiding adjuvant therapy.
- Post-Mastectomy Radiation (PMRT): Indicated for high-risk features: tumor >5 cm, positive margins, or significant nodal disease (≥4 nodes).
⭐ Mastectomy is the rule for men. Unlike in female breast cancer, skin-sparing or nipple-sparing techniques are generally avoided due to the high incidence of central tumor location.

⚡ Biggest Takeaways
- BRCA2 is the most significant genetic risk factor; Klinefelter syndrome is also high-yield.
- Typically presents as a painless, subareolar mass in older men (average age ~70).
- Histology is almost always Infiltrating Ductal Carcinoma (IDC).
- Most tumors are hormone receptor-positive (ER+/PR+), guiding therapy with tamoxifen.
- Standard treatment is mastectomy, not lumpectomy, due to small breast size.
- Prognosis is similar to females stage-for-stage but often diagnosed at a later stage.
Unlock the full lesson and continue reading
Signup to continue reading this lesson and unlimited access questions, flashcards, AI notes, and more